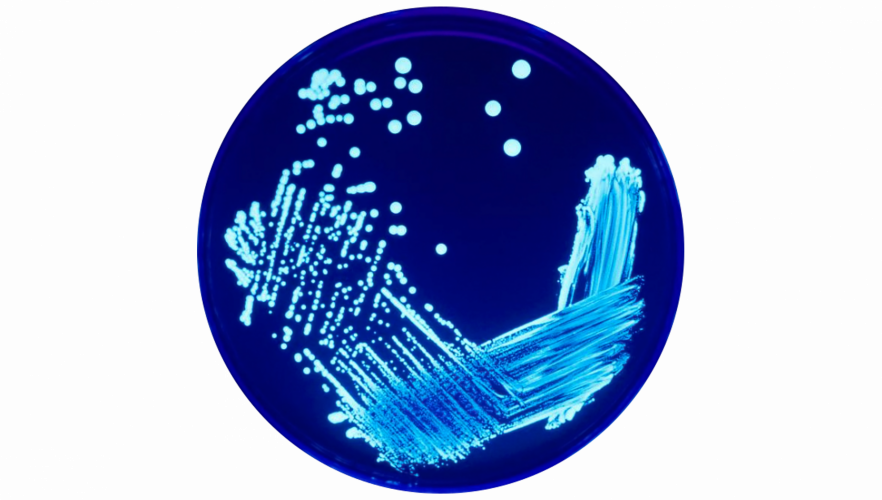

Models
Models are approximations of reality. But sometimes, we encounter nothing less than truth.

Power Line Transmission Losses
Running power lines on high voltage reduces the losses. But way too often the explanations of the underlying mechanism omit crucial elements or are just plainly wrong. Here is how it really works.

The Art of Doing Science and Engineering – Learning to Learn by Richard W. Hamming
Review of The Art of Doing Science and Engineering - Learning to Learn by Richard W. Hamming

Solving differential equations numerically. Part 2: Euler’s method
See how to use Euler's method to solve differential equations.

Solving differential equations numerically. Part 1: SciPy’s solve_ivp
Introduction to solving differential equations using solve_ivp from the Python library Scipy

The Physics of a Bicycle Accident
Now it happened. After about 1,700 km on the bike this year, I had an accident. In Kuchl (in most beautiful Salzburg, Austria), I did a relatively sharp turn on starting when the front wheel came...

Newton’s Law of Universal Gravitation
The force of gravity holds the Earth and the Moon in their orbits and our feet on the ground. The physical law behind it that Isaac Newton came up with is almost deceptively simple. Still, it...
Separation of Variables
Whereas most differential equations can only be solved by way of numerical approximation, some have a mathematically exact – analytical – solution. The separation of variables lets us solve the differential equation e. g. of exponential...
